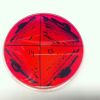

-
 +22 +2
+22 +2The First Major Review of Menstrual Cups Has Just Given Its Verdict
In the last few years, menstrual cups have emerged as an eco-friendly alternative to disposable pads and tampons. Rather than absorbing menstrual blood, these flexible silicone cups collect it from within the vagina, and they can last for up ten years
-
 +26 +6
+26 +61 in 10 patients are infected in hospital, and it's not always with what you think
A surprising number of people are catching pneumonia or urinary tract infections in hospital, a new Australian study shows for the first time.
-
 +31 +6
+31 +6The Human Impact Of Having Too Few Nurses
By Lucy Maddox. This new research adds to a body of evidence that takes the blame off the nurse and squarely places the responsibility on the system to do better.
-
 +2 +1
+2 +1Top 5 Digital Transformation Trends for Healthcare Industry in 2019
Artificial Intelligence, Virtual Reality, Internet of Things and blockchain technology are shaping the current healthcare industry. Find out how tech trends benefited medical sphere today.
-
 +11 +1
+11 +1The US Health System Is a Nightmare Where 50 Million Go Uninsured Every Single Year
Anyone who says they’re worried about people losing their health insurance because of Medicare for All is being disingenuous: every year, under our current system, 50 million lack insurance at some point. The only solution to that insecurity is Medicare for All.
-
 +2 +1
+2 +1Top 10 Best Apps for Stress Management
Our team picked up the best mobile apps for stress management and your mental recharge. Check them out!
-
 +18 +3
+18 +3What Does That DNR Really Mean? w/Dr. Fred Mirarchi | Incident Report 246
We routinely misinterpret patients' wishes around medical interventions. Dr. Fred Mirarchi may have a way to fix that.
1 comments by Gozzin -
 +18 +3
+18 +3What if AI in health care is the next asbestos?
Artificial intelligence is often hailed as a great catalyst of medical innovation, a way to find cures to diseases that have confounded doctors and make health care more efficient, personalized, and accessible. But what if it turns out to be poison?
-
 +15 +3
+15 +3Faces of Antimicrobial Resistance: The Human Cost of Antimicrobial Resistance
Antimicrobial Resistance; patient stories; antibiotic resistant infections;
-
+10 +3
+10 +3Salmonella Resistant to Antibiotics of Last Resort Found in U.S.
A gene that gives Salmonella resistance to antibiotics of last resort has been found in a sample taken from a human patient in the U.S.
-
 +21 +3
+21 +3Patient dies from fecal transplant containing drug-resistant bacteria
The donor stool had not been tested for the drug-resistant bacteria before the procedure, the FDA noted.
-
 +26 +3
+26 +3Health Workers Still Aren't Alerting Police About Likely Elder Abuse, Reports Find
Workers in nursing homes, hospital ERs and other health facilities are required by law to notify police whenever they notice likely signs of physical or sexual abuse. But that's often not happening.
-
 +10 +1
+10 +1The Unfixable Doctor-Patient Relationship
Fringe practitioners will tell you what you want to hear; medical doctors will tell you what you need to hear.
-
 +8 +2
+8 +2Quest and AMCA Leak 12M Blood-Test Patients' Data
Millions of people might have had their financial and medical information stolen due to a Quest Diagnostics and AMCA data breach.
-
 +29 +5
+29 +5Physician Burnout Costs the U.S. Billions of Dollars Each Year
Burnout, characterized by emotional exhaustion as well as feeling cynical, ineffective or unaccomplished at work, is bad for both employees and employers. For doctors and hospitals, though, the ramifications can be especially dire. Doctors in the U.S. experience symptoms of burnout at almost twice the rate of other workers, often citing as contributors the long hours, a fear of being sued, and having to deal with growing bureaucracy...
-
 +6 +2
+6 +2Importance of Detecting Irritable Bowel-like Symptoms in Inflammatory Bowel Disease Patients
Symptoms of IBD, such as abdominal pain and diarrhoea, frequently mimic or overlap those of irritable bowel syndrome [IBS] and therefore IBD patients with concomitant IBS pose a diagnostic and therapeutic dilemma for many physicians.
-
 +5 +1
+5 +1U.S. Births Fall to Lowest Level Since 1980s
The number of babies born in the U.S. last year fell to a 32-year low, deepening a fertility slump that is reshaping America’s future workforce. About 3.79 million babies were born in the U.S. in 2018, according to provisional data from the Centers for Disease Control and Prevention’s National Center for Health Statistics.
-
 +15 +2
+15 +2The Hidden World of the Doctors Cuba Sends Overseas
Thousands of Cuban doctors work in healthcare missions around the world. Some medics say conditions can be nightmarish.
-
 +19 +4
+19 +4Machine learning predicts heart attacks with 90% accuracy | Verdict
Using data from 950 patients with chest pain, researchers from the University of Turku, Finland, were able to train an algorithm to identify patterns that indicate a higher propensity for heart attacks and cardiac-related deaths. The outcome of these patients was known over a six-year period, which meant the researchers were able to know with certainty if the predictions were accurate.
-
 +9 +1
+9 +1There's a Bizarre Link Between Losing Your Appendix And Developing Parkinson's, Huge Study Shows
There seems to be a link between the degenerative neurological disorder Parkinson's disease and your appendix. Just what that relationship might be, nobody can agree upon, but here's what we know so far.
Submit a link
Start a discussion




















